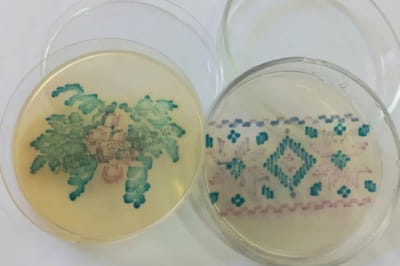
Вишивка

Цікаво, що такий жест, як поцілунок, зустрічається тільки у людей і не є характерним для інших видів у тваринному світі. Про це розповість "Дивогляд" із посиланням на Daily Mail.
Нове дослідження
Еволюційний психолог з Університету Уорік Адріано Ламейра припустив, що поцілунок може мати зовсім не романтичне чи сексуальне походження. Він вважає, що наші доісторичні предки почали обмінюватися "поцілунками" мільйони років тому, але з іншою метою – доглядом за шерстю та видаленням паразитів.
На думку Ламейри, первісні рухи, схожі на поцілунок, слугували для видалення вошей і очищення шерсті. Цей метод був поширеним серед наших волохатих предків і застосовувався для підтримки гігієни. За мільйони років цей жест еволюціонував, і його початковий сенс втратив свою актуальність, залишивши лише жест із висунутими вперед губами.
Так, наші пращури, які ще мали густе хутро, могли цілувати не тільки губи одне одного, а й інші частини тіла під час процесу догляду. Однак через поступове зменшення покриву цей ритуал скоротився до кінцевої фази – контакту рот у рот. Зі зміною зовнішнього вигляду людини, особливо через втрату шерсті, потреба в таких ритуалах відпала, проте остання стадія "догляду" залишилася, трансформувавшись у поцілунок, який ми знаємо сьогодні.

"Значення такої ритуальної поведінки знизилося з часом, коли еволюційно людство втратило шерсть. Але фінальний етап цього ритуалу, поцілунок рот у рот, став своєрідною спадщиною і залишився важливим для зміцнення соціальних зв’язків серед предків", – зауважив Ламейра.
Вчений також припускає, що така форма догляду за собою з'явилася близько 7 мільйонів років тому, коли пращури людини почали переходити від життя на деревах до наземного середовища. Це нове середовище зумовило більшу загрозу паразитарного навантаження, тому очищення стало важливою частиною поведінкових ритуалів.
Коли відбувся остаточний перехід від ритуального очищення до поцілунку, залишається невідомим. Вважається, що близько 2-4 мільйонів років тому, з повною втратою шерсті, цей контакт рот у рот залишився єдиною ознакою давнього обряду.
Дослідження вказує на те, що сексуальний підтекст поцілунків, ймовірно, виник пізніше. Ламейра вважає, що на ранньому етапі поцілунок був універсальним способом прояву прихильності та виконував соціальну функцію, яка згодом розвинулася в інтимний жест.
"Сексуальні поцілунки є лише однією з численних форм поведінки, пов’язаної з прихильністю. Лише коли поцілунки стали частиною спілкування та прояву емоцій, вони отримали сучасне значення", – підсумовує Ламейра.
Цікаво, що у тваринному світі такий жест, як поцілунок, не має сексуального підтексту. Люди є єдиним видом, який використовує цей акт, як символ інтимності та емоційної прив'язаності.
Раніше "Дивогляд" розповідав про цікаву історію Дня поцілунків та традиції цього свята.
Поки на нашій землі війна, навіть "Дивогляд" – це не про котиків і пандочок, а про перемоги нашого війська! Наш Telegram – Дивогляд 5.UA.